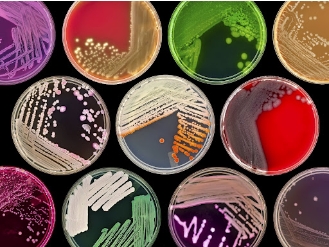

微生物挑戰(zhàn)性實(shí)驗(yàn)
微生物挑戰(zhàn)實(shí)驗(yàn)已經(jīng)并將繼續(xù)是確定食品是否支持腐敗微生物或病原體生長(zhǎng)能力的一個(gè)有用工具。微生物挑戰(zhàn)實(shí)驗(yàn)還是針對(duì)靶生物或一組靶生物具有殺傷力過程能力驗(yàn)證的重要手段。通常,實(shí)驗(yàn)后的目的是必然發(fā)布一個(gè)有關(guān)殺傷力過程的性能指標(biāo)(例如:對(duì)發(fā)酵肉制品中大腸桿菌O157:H7減少5個(gè)對(duì)數(shù)值)。設(shè)計(jì)適當(dāng)?shù)奈⑸锾魬?zhàn)實(shí)驗(yàn)將驗(yàn)證具體過程是符合預(yù)定的性能指標(biāo)。微生物挑戰(zhàn)研究的設(shè)計(jì)、實(shí)施和評(píng)估是一個(gè)復(fù)雜的任務(wù),取決于相關(guān)的產(chǎn)品是如何開發(fā)、制造、包裝、交付、制備和消費(fèi)等因素。
廈門中集信檢測(cè)技術(shù)有限公司具備多年的行業(yè)檢測(cè)經(jīng)驗(yàn),擁有先進(jìn)的技術(shù)、設(shè)備及檢測(cè)測(cè)試人員,獲得多次國(guó)內(nèi)外權(quán)威能力驗(yàn)證的肯定,以及合作伙伴的信賴,可以依據(jù)中國(guó)國(guó)家食品標(biāo)準(zhǔn)及食品行業(yè)公認(rèn)的國(guó)內(nèi)外權(quán)威的標(biāo)準(zhǔn)方法,為客戶提供多種測(cè)試項(xiàng)目,并為客戶提供特定的檢測(cè)方法。
檢測(cè)項(xiàng)目
詳情請(qǐng)咨詢熱線:0592-7253852
適用范圍
農(nóng)產(chǎn)品;食品;環(huán)境/水工業(yè);海水
檢測(cè)標(biāo)準(zhǔn)
國(guó)標(biāo)、歐盟標(biāo)準(zhǔn)、日本法規(guī)、美國(guó)法規(guī)
主要設(shè)備
潔凈工作臺(tái)、生物安全柜、電熱恒溫培養(yǎng)箱、顯微鏡